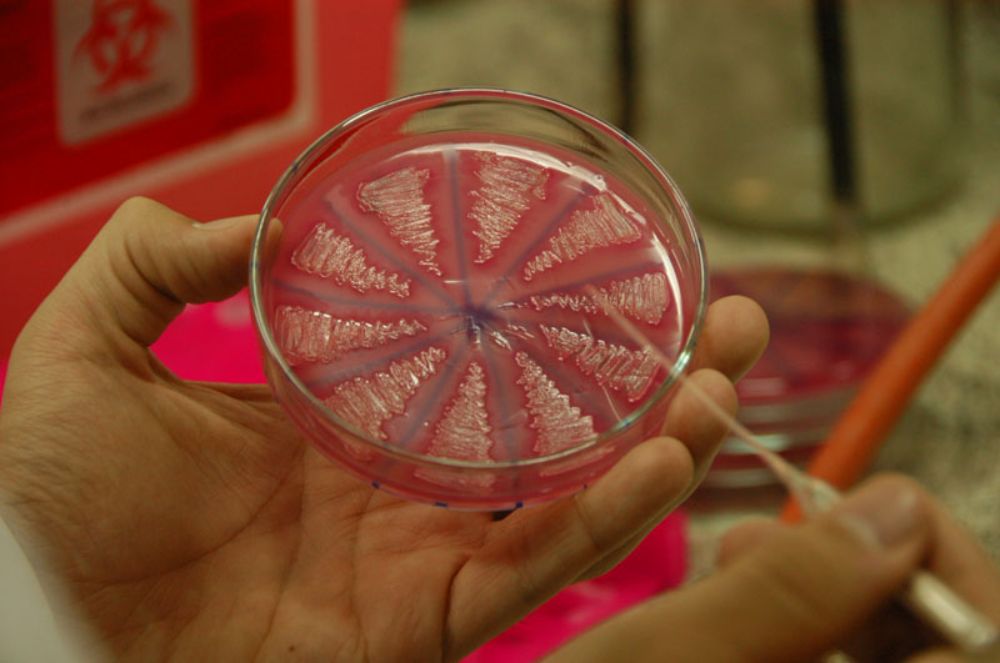
Organizaciones y sociedades científicas

Organizaciones y sociedades científicas
- Vicerrectoría de Investigación y Desarrollo
- Comisión Nacional de Investigación Científica y Tecnológica (CONICYT)
- Corporación de Fomento de la Producción (CORFO)
- Fondo Nacional de Investigación y Desarrollo en Salud (FONIS)
- Fondo de Fomento al Desarrollo Científico y Tecnológico (FONDEF)
- Fondo Nacional de Desarrollo Científico y Tecnológico (FONDECYT)
- Academia Chilena de Ciencias
- Asociación Chilena de Inmunología
- Sociedad Chilena de Anatomía Patológica
- Sociedad Chilena de Biología y Medicina Nuclear
- Sociedad Chilena de Cardiología y Cirugía Cardiovascular
- Sociedad Chilena de Ciencias Fisiológicas
- Sociedad Chilena de Cirugía Pediátrica
- Sociedad Chilena de Cirugía Plástica Reconstructiva y Estética
- Sociedad Chilena de Dermatología y Venerología
- Sociedad Chilena de Endocrinología y Metabolismo
- Sociedad Chilena de Enfermedades Respiratorias
- Sociedad Chilena de Evolución
- Sociedad Chilena de Gastroenterología
- Sociedad Chilena de Hematología
- Sociedad Chilena de Infectología
- Sociedad Chilena de Medicina Física y Rehabilitación
- Sociedad Chilena de Nefrología
- Sociedad Chilena de Obstetricia y Ginecología
- Sociedad Chilena de Oftalmología
- Sociedad Chilena de Ortopedia y Traumatología
- Sociedad Chilena de Otorrinolaringología, Medicina y Cirugía de Cabeza y Cuello
- Sociedad Chilena de Pediatría
- Sociedad Chilena de Química
- Sociedad Chilena de Radiología
- Sociedad Chilena de Reproducción y Desarrollo
- Sociedad Chilena de Reumatología
- Sociedad Chilena de Urología
- Sociedad de Anestesiología de Chile
- Sociedad de Biología Celular de Chile
- Sociedad de Biología de Chile
- Sociedad de Bioquímica y Biología Molecular de Chile
- Sociedad de Botánica de Chile
- Sociedad de Cirujanos de Chile
- Sociedad de Ecología de Chile
- Sociedad de Farmacología de Chile
- Sociedad de Genética de Chile
- Sociedad de Neurocirugía de Chile
- Sociedad de Neurología, Psiquiatría y Neurocirugía
- Sociedad de Psiquiatría y Neurología de la Infancia y Adolescencia
- Sociedad Médica de Santiago
- Sociedad de Microbiologia de Chile